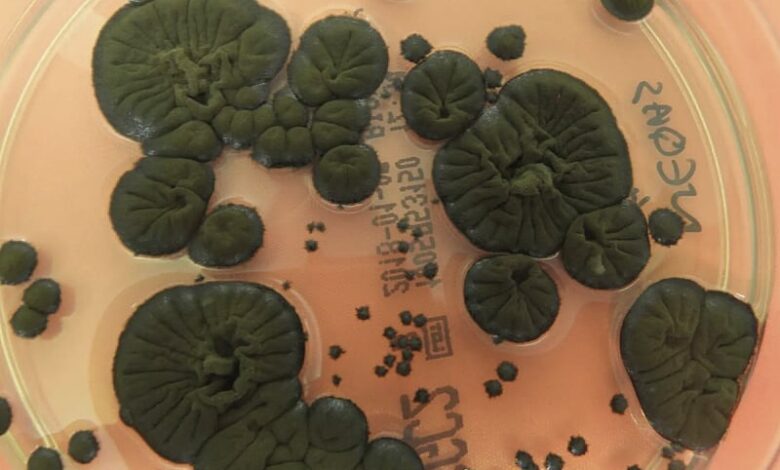

Černobilska crna gljiva pretvara nuklearno zračenje u energiju, mogla bi pomoći astronautima
Katastrofa se dogodila 26. aprila 1986. godine, kada je rutinski sigurnosni test u černobilskom reaktoru 4 prerastao u najgoru nuklearnu nesreću na svijetu, koja je uzrokovana greškama u dizajnu i radu.
Da bi se ublažilo trovanje zračenjem, uspostavljena je “zona isključenja” od 30 km, koja drži ljude dalje od opasnosti. Uprkos riziku, neki istraživači su proveli studije o tome kako zračenje utiče na okolno okruženje.
Na primjer, 1997. godine je ukrajinska mikologinja Nelli Zhdanova otkrila crnu plijesan koja kolonizira visoko radioaktivne ruševine černobilske nuklearne elektrane rastući po zidovima, plafonima, pa čak i unutar zgrade reaktora.
Istraživanje je pokazalo da gljive privlači jonizirajuće zračenje.
Ovo izvanredno otkriće da život može napredovati i rasti u prisustvu zračenja, dovelo je u pitanje ustaljene ideje o otpornosti života, a također je predstavilo potencijal za korištenje ove plijesni u primjenama kao što su čišćenje radioaktivnih mjesta i zaštita astronauta od kosmičkog zračenja u svemiru.
Jonizirajuće zračenje, koje obično uništava DNK i ćelije, izgledalo je kao hranjiva tvar za ove otporne gljive.
Čini se da je tajna zapravo melanin. Isti pigment koji ljudima daje različite tonove kože i štiti od UV zraka nalazi se u ćelijskim zidovima ovih černobilskih gljiva.
Početne teorije sugerisale su da melanin štiti crnu plijesan, međutim, studija nuklearnog naučnika iz 2007. godine otkrila je ključni nalaz. Melanizirane gljive rasle su 10 posto brže kada su bile izložene radioaktivnom ceziju, što sugeriše da su aktivno koristile zračenje za metaboličku energiju. Ovaj proces nazvan je radiosinteza.
“Energija jonizirajućeg zračenja je oko milion puta veća od energije bijele svjetlosti, koja se koristi u fotosintezi. Dakle, potreban vam je prilično snažan pretvarač energije, i to je ono što mislimo da melanin može učiniti, pretvoriti jonizirajuće zračenje u upotrebljive nivoe energije”, rekla je za BBC nuklearna naučnica Ekaterina Dadachova.
Dalja istraživanja su otkrila da ne pokazuju sve melanizirane gljive ovo ponašanje, a jedna studija čak nije pronašla razliku u rastu kod testiranih gljiva kada su izložene zračenju.
Zaintrigirana međunarodna naučna zajednica poslala je uzorke Cladosporium sphaerospermum, istog soja pronađenog u Černobilu, na Međunarodnu svemirsku stanicu (ISS).
Ono što se sljedeće dogodilo učvrstilo je kosmički potencijal plijesni. Suočene s intenzivnim kosmičkim zračenjem, gljive su napredovale, pokazujući stopu rasta 1,21 puta veću od kontrolnih uzoraka na tlu.
Zanimljivo je da je eksperiment na ISS-u također pokazao potencijal plijesni kao zaštitne barijere. Kako su se gljive razvijale, štitile su od značajne količine zračenja u poređenju s kontrolnim područjima.
Iz ovih eksperimenata, stručnjaci sugerišu da uočene radioprotektivne koristi plijesni možda nisu isključivo posljedica melanina, već moguće i drugih bioloških komponenti poput vode.
Galaktičko kosmičko zračenje, oluja brzih nabijenih protona iz eksplodirajućih zvijezda, predstavlja “najveću opasnost” za astronaute koji se upuštaju u putovanje izvan Zemljine zaštitne atmosfere.
Standardna rješenja zaštite, poput teških metala, skupa su i teška za lansiranje u svemir. Ipak, ovaj černobilski kalup nudi jednostavnu, biološku alternativu.
Astrobiologinja NASA-e Lynn J. Rothschild zamišlja “miko-arhitekturu”, staništa uzgojena od gljiva na Mjesecu ili Marsu. Ovi živi zidovi ne bi bili samo strukturni, oni bi bili samoregenerirajući radijacijski štitovi uzgojeni “in situ”, što bi drastično smanjilo troškove lansiranja.
Nakon što su kolonizirale toksično mjesto poput Černobila, ove gljive bi u konačnici mogle zaštititi astronaute u bliskoj budućnosti.
klix


